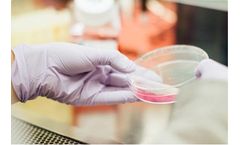
Bioconservacion - Application Consultancy Services

- Home
- Services
Refine by
Bioconservacion Environmental Industry Services
3 services found
Manufactured by:Bioconservacion SA based inGavà, SPAIN
In the laboratory we have the necessary technical resources to simulate the real conditions of a given environment. The test equipment can be carried out on OEM and refrigerated equipment with the highest possible reliability. With the information resulting from the tests, the most advantageous solutions are proposed for each ...
Manufactured by:Bioconservacion SA based inGavà, SPAIN
Thanks to our extensive experience we can offer consulting services where we research and advise on products or combinations of products that work specifically for the application being ...
Manufactured by:Bioconservacion SA based inGavà, SPAIN
At our headquarters in Gavà, Barcelona (Spain), we research, develop and manufacture ad-hoc solutions for our ...